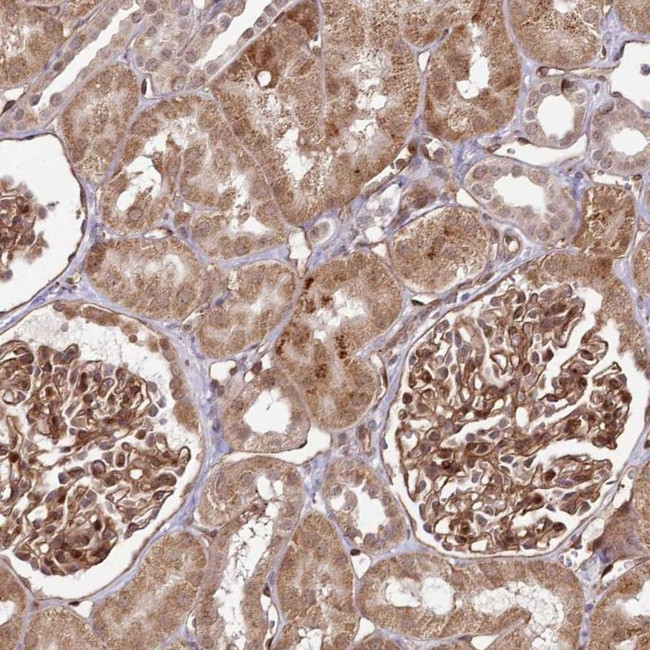
COPG Antibody in Immunohistochemistry (IHC)

Search
Invitrogen
COPG Polyclonal Antibody
{{$productOrderCtrl.translations['antibody.pdp.commerceCard.promotion.promotions']}}
{{$productOrderCtrl.translations['antibody.pdp.commerceCard.promotion.viewpromo']}}
{{$productOrderCtrl.translations['antibody.pdp.commerceCard.promotion.promocode']}}: {{promo.promoCode}} {{promo.promoTitle}} {{promo.promoDescription}}. {{$productOrderCtrl.translations['antibody.pdp.commerceCard.promotion.learnmore']}}



Please note: We are reviewing Western blot images included in the antibody testing data in our catalog, including those provided by third parties. Unless expressly labeled or annotated as “raw-unedited”, Western blot images included in the antibody testing data in our catalog may have been edited, optimized or otherwise adjusted for presentation.
产品信息
PA5-58146
种属反应
宿主/亚型
分类
类型
抗原
偶联物
形式
浓度
规格
纯化类型
保存液
内含物
保存条件
运输条件
RRID
产品详细信息
Immunogen sequence: VKQPEKVAAT RQEIFQEQLA AVPEFRGLGP LFKSSPEPVA LTESETEYVI RCTKHTFTNH MVFQFDCTNT LNDQTLENVT VQMEPTE
Highest antigen sequence identity to the following orthologs: Mouse - 95%, Rat - 95%.
靶标信息
The coatomer is a cytosolic protein complex that binds to dilysine motifs and reversibly associates with Golgi non-clathrin-coated vesicles, which further mediate biosynthetic protein transport from the ER, via the Golgi up to the trans Golgi network. Coatomer complex is required for budding from Golgi membranes, and is essential for the retrograde Golgi-to-ER transport of dilysine-tagged proteins. In mammals, the coatomer can only be recruited by membranes associated to ADP-ribosylation factors (ARFs), which are small GTP-binding proteins; the complex also influences the Golgi structural integrity, as well as the processing, activity, and endocytic recycling of LDL receptors. Required for limiting lipid storage in lipid droplets. Involved in lipid homeostasis by regulating the presence of perilipin family members PLIN2 and PLIN3 at the lipid droplet surface and promoting the association of adipocyte triglyceride lipase (PNPLA2) with the lipid droplet surface to mediate lipolysis. [UniProt]
仅用于科研。不用于诊断过程。未经明确授权不得转售。
篇参考文献 (0)
生物信息学
蛋白别名: coat protein gamma-cop; coatomer protein complex subunit gamma 1; coatomer protein complex, subunit gamma; coatomer subunit gamma; Coatomer subunit gamma-1; COPI coat complex subunit gamma 1; Gamma-1-coat protein; Gamma-1-COP; gamma-coat protein; gamma-COP; unnamed protein product
基因别名: AU019265; BC056168; COPG; COPG1; D6Ertd71e; D6Wsu16e; IMD128
UniProt ID: (Mouse) Q9QZE5, (Rat) Q4AEF8
Entrez Gene ID: (Human) 22820, (Mouse) 54161, (Rat) 297428